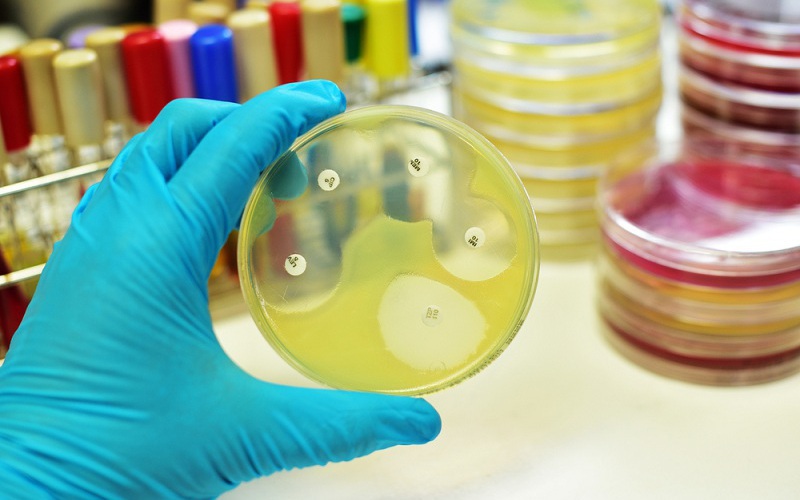

Phòng khám Đa khoa Medlatec Tây Hồ (Hà Nội) vừa điều trị thành công cho một bệnh nhân bị viêm mũi xoang cấp do loại vi khuẩn siêu kháng kháng sinh gây ra.

Khoảng 2 tháng nay, bệnh nhân C.T.K.T. (nữ, 60 tuổi, trú tại Hà Nội) có biểu hiện đau đầu vùng hốc mắt, trán, chảy mũi đặc số lượng nhiều, ngạt mũi, ù tai. Bệnh nhân đã đi khám tại cơ sở y tế gần nhà, được chẩn đoán viêm mũi xoang cấp và điều trị theo đơn thuốc của bác sĩ. Tuy nhiên, sau 2 đợt điều trị kháng sinh, thấy tình trạng vẫn không thuyên giảm, lo lắng nên bệnh nhân đến khám tại Phòng khám Đa khoa Maclatec Tây Hồ.
Tại phòng khám, bệnh nhân được tiến hành thăm khám lâm sàng, nội soi tai mũi họng và cấy mủ đánh giá chính xác căn nguyên nhiễm trùng. Kết luận, ekip bác sĩ chẩn đoán xác định bệnh nhân mắc viêm mũi xoang cấp do vi khuẩn tụ cầu (Staphylococcus) gây ra.
Ngay sau đó, ekip bác sĩ chỉ định bệnh nhân làm xét nghiệm kháng sinh đồ giúp xác định chính xác mức độ nhạy cảm của các loại kháng sinh với vi khuẩn, từ đó, đưa ra phác đồ điều trị phù hợp, tránh quay lại tình trạng như 2 đợt điều trị trước đó.
Kết quả, nhờ hướng xử trí đúng đắn của các bác sĩ, bệnh nhân khỏi bệnh hoàn toàn chỉ sau 1 tuần điều trị ngoại trú theo đơn thuốc.
Bác sĩ Nguyễn Đình Hiệp – Chuyên khoa Tai mũi họng lý giải nguyên nhân thất bại của 2 lần điều trị tại cơ sở y tế trước: Tình trạng viêm mũi xoang của bệnh nhân do vi khuẩn tụ cầu gây ra, đây là loại vi khuẩn có sức đề kháng mạnh với kháng sinh. Do đó, nếu bác sĩ không tìm ra loại kháng sinh phù hợp sẽ khiến bệnh nhân không đáp ứng thuốc và tình trạng bệnh diễn tiến nặng hơn.
Vi khuẩn tụ cầu nguy hiểm như thế nào?
Vi khuẩn tụ cầu (Staphylococcus) là một trong những tác nhân gây ra hiện tượng nhiễm trùng ở người. Vi khuẩn này có ở mọi nơi trong môi trường tự nhiên, đặc biệt vào mùa hè khi thời tiết nóng ẩm.
Thông thường, tụ cầu vẫn xuất hiện trên cơ thể người (chủ yếu trên da) nhưng không gây bệnh, hoặc chỉ nhiễm trùng da nhẹ. Tuy nhiên, khi vi khuẩn xâm nhập sâu hơn vào máu, khớp, phổi hay tim có thể dẫn đến tình trạng nhiễm trùng nghiêm trọng, gây nguy hiểm đến tính mạng người bệnh.
Bác sĩ Nguyễn Đình Hiệp cho biết: Hiện nay có khoảng 32 loài tụ cầu, trong đó tụ cầu vàng là loài phổ biến nhất, thường ký sinh ở da/ mũi họng và gây bệnh cho những người bị suy giảm sức đề kháng. Đặc biệt, hầu hết tụ cầu vàng đều đề kháng với nhiều loại kháng sinh khác nhau, gây khó khăn trong quá trình điều trị.
Khi nhiễm khuẩn tụ cầu, người bệnh có thể gặp phải các tình trạng phổ biến sau:
Nhiễm khuẩn da: Các tụ cầu thường sống ký sinh trên da và niêm mạc nên dễ dàng xâm nhập qua lỗ chân lông/ chân tóc/ tuyến dưới da, gây ra các ổ áp xe/ mụn nhọt.
Nhiễm khuẩn huyết: Vi khuẩn tụ cầu gây nhiễm khuẩn ngoài da có khả năng di chuyển vào máu gây nhiễm khuẩn máu. Đây là tình trạng nguy hiểm, bởi lúc này tụ cầu dễ dàng xâm lấn đến các nội tạng như gan, phổi, não, tủy… gây ra ổ áp xe tại các cơ quan này.
Ngộ độc thức ăn và viêm ruột cấp: Tụ cầu khi nhiễm vào thực phẩm có khả năng sinh sôi nhanh chóng, đặc biệt, ở mức nhiệt 100°C trong vòng 15 phút vẫn có khả năng hoạt động. Khi ăn phải thực phẩm nhiễm tụ cầu có thể gây ra tình trạng ngộ độc thức ăn, viêm ruột cấp, với các biểu hiện thường gặp như: đau bụng bất thường, buồn nôn, tiêu chảy, chán ăn, sốt nhẹ…
Hội chứng sốc nhiễm độc: Hội chứng này thường gặp ở phụ nữ trong kỳ kinh nguyệt khi sử dụng băng vệ sinh bị nhiễm khuẩn tụ cầu. Đây là hội chứng hiếm gặp, có tính chất đột ngột, gây nguy hiểm tính mạng cho người bệnh, với các triệu chứng như: sốt cao, đau đầu, mệt mỏi, khát nước, tim đập nhanh, hạ huyết áp, nổi mẩn khắp cơ thể…
Nguồn: vtv.vn